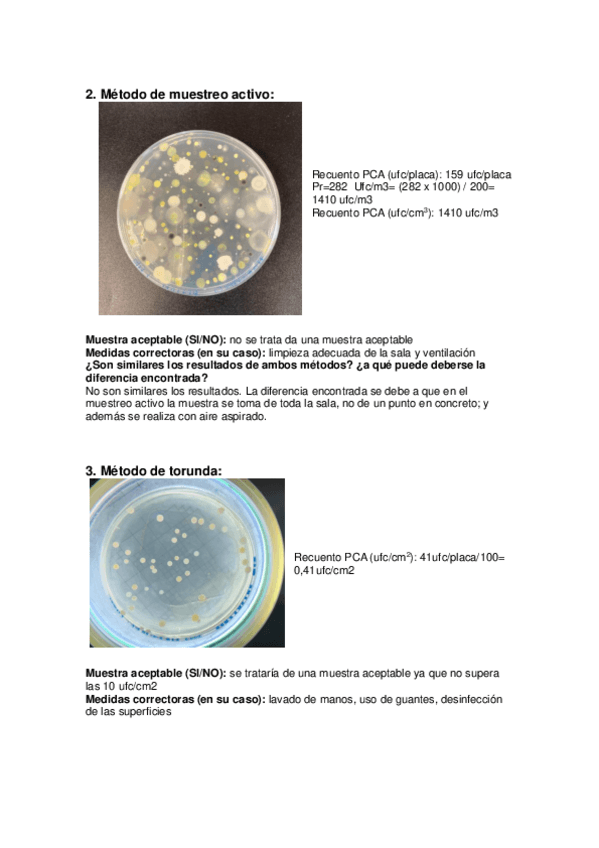

Higiene Alimentaria
He publicado nuevos apuntes de 4º Higiene Alimentaria: RESUMEN-HIGIENE.pdf
He publicado nuevos examenes de 4º Higiene Alimentaria: Higiene-230125.pdf
He publicado nuevos apuntes de 4º Higiene Alimentaria: Legislacion-20252026.pdf
apuntes
-
Higiene
He publicado nuevos apuntes de 4º Higiene Alimentaria: Higiene
practicas
-
Test prácticas
He publicado nuevos practicas de 4º Higiene Alimentaria: Test prácticas
apuntes
-
Bloque 3
He publicado nuevos apuntes de 4º Higiene Alimentaria: Bloque 3
test
-
Test clase
He publicado nuevos test de 4º Higiene Alimentaria: Test clase
apuntes
-
APUNTES HIGIENE 23/24
He publicado nuevos apuntes de 4º Higiene Alimentaria: APUNTES HIGIENE 23/24
He publicado nuevos test de 4º Higiene Alimentaria: Seminario-vida-util-P.8-cuestionario.pdf
apuntes
-
Bloque II
He publicado nuevos apuntes de 4º Higiene Alimentaria: Bloque II
apuntes
-
Bloque I
He publicado nuevos apuntes de 4º Higiene Alimentaria: Bloque I
apuntes
-
Bloque III
He publicado nuevos apuntes de 4º Higiene Alimentaria: Bloque III
apuntes
-
Bloque 1
He publicado nuevos apuntes de 4º Higiene Alimentaria: Bloque 1
Test seminario criterios microbiológicos (practica 3 25/26)
apuntes
-
Temario
He publicado nuevos apuntes de 4º Higiene Alimentaria: Temario
He publicado nuevos apuntes de 4º Higiene Alimentaria: Informe-practica-de-laboratorio.-Contaminacion-abiotica.pdf
He publicado nuevos apuntes de 4º Higiene Alimentaria: Informe-analisis-microbiologico.pdf
He publicado nuevos apuntes de 4º Higiene Alimentaria: Informe-de-practicas-higiene.pdf
He publicado nuevos apuntes de 4º Higiene Alimentaria: RECAP-DESARROLLO-HIGIENE-2025.pdf
He publicado nuevos examenes de 4º Higiene Alimentaria: RECOPILACION-LARGAS.pdf
He publicado nuevos examenes de 4º Higiene Alimentaria: RECOPILACION-TEST-RESUELTO.pdf
He publicado nuevos examenes de 4º Higiene Alimentaria: RECOPILACION-TEST.pdf
He publicado nuevos apuntes de 4º Higiene Alimentaria: Esquema tóxicos naturales.pdf
He publicado nuevos apuntes de 4º Higiene Alimentaria: RECOPILACION-PREGUNTAS-LARGAS-DE-HIGIENE.pdf
He publicado nuevos apuntes de 4º Higiene Alimentaria: Test-de-febrero-2024.pdf
He publicado nuevos test de 4º Higiene Alimentaria: CUESTIONARIO-REGLAMENTO.pdf
He publicado nuevos apuntes de 4º Higiene Alimentaria: Preguntas-desarrollo-enero-y-febrero-2024.pdf
He publicado nuevos apuntes de 4º Higiene Alimentaria: Apartados-importantes.pdf
apuntes
-
RECOPILACION DE TEST
He publicado nuevos apuntes de 4º Higiene Alimentaria: RECOPILACION DE TEST
apuntes
-
TODOS LOS CUESTIONARIOS/TEST HIGIENE
He publicado nuevos apuntes de 4º Higiene Alimentaria: TODOS LOS CUESTIONARIOS/TEST HIGIENE
He publicado nuevos apuntes de 4º Higiene Alimentaria: Autoevaluacion-Test-Recopilacion.pdf
He publicado nuevos apuntes de 4º Higiene Alimentaria: Practica-1-lechuga.pdf
He publicado nuevos apuntes de 4º Higiene Alimentaria: Informe-practica-4-higiene.pdf
He publicado nuevos examenes de 4º Higiene Alimentaria: RECOPILACION TEST POR BLOQUES CORREGIDO.pdf
apuntes
-
Esquemas
He publicado nuevos apuntes de 4º Higiene Alimentaria: Esquemas
He publicado nuevos apuntes de 4º Higiene Alimentaria: Casos-practicos-seminario-Brotes-Alimentarios.pdf
He publicado nuevos apuntes de 4º Higiene Alimentaria: Aditivo-vs-coadyuvante-tecnologico-Cloruro-calcico-Revision-del-intento.pdf
He publicado nuevos apuntes de 4º Higiene Alimentaria: HAPs-y-3-MCPD-glicidol-y-sus-esteres-Revision-del-intento.pdf
He publicado nuevos apuntes de 4º Higiene Alimentaria: Cuestionario-sobre-las-medidas-de-prevencion-de-la-aparicion-de-micotoxinas-en-especias-y-cereales.pdf
He publicado nuevos practicas de 4º Higiene Alimentaria: Seminario-Criterios-microbiologicos-ppt-con-apuntes--casos-practicos.pdf
apuntes
-
Food Hygiene
He publicado nuevos apuntes de 4º Higiene Alimentaria: Food Hygiene
He publicado nuevos examenes de 4º Higiene Alimentaria: Test-higiene-bilingue-enero.pdf
He publicado nuevos apuntes de 4º Higiene Alimentaria: recopilatorio-preguntas-largas.pdf
He publicado nuevos apuntes de 4º Higiene Alimentaria: Preguntas-mas-frecuentes.pdf
He publicado nuevos examenes de 4º Higiene Alimentaria: EXAMEN-ENERO-2023-RESUELTO-testlargas.pdf
He publicado nuevos apuntes de 4º Higiene Alimentaria: Resumenes-Food-Hygiene.pdf
apuntes
-
Prácticas higiene
He publicado nuevos apuntes de 4º Higiene Alimentaria: Prácticas higiene
He publicado nuevos apuntes de 4º Higiene Alimentaria: Preguntas-desarrollo-bilingue-enero-2023.pdf
He publicado nuevos apuntes de 4º Higiene Alimentaria: RECOPILATORIO-PREGUNTAS-TEORIA.pdf
He publicado nuevos apuntes de 4º Higiene Alimentaria: test-higiene-resuelto-bilingue.pdf
apuntes
-
Higiene Alimentaria 22-23
He publicado nuevos apuntes de 4º Higiene Alimentaria: Higiene Alimentaria 22-23
He publicado nuevos apuntes de 4º Higiene Alimentaria: Largas-higiene..pdf
He publicado nuevos apuntes de 4º Higiene Alimentaria: Mapas-Mentales-Higiene.pdf
He publicado nuevos practicas de 4º Higiene Alimentaria: INFORMES-LABORATORIO-P4.pdf
He publicado nuevos apuntes de 4º Higiene Alimentaria: TEST-PRACTICA-4.pdf